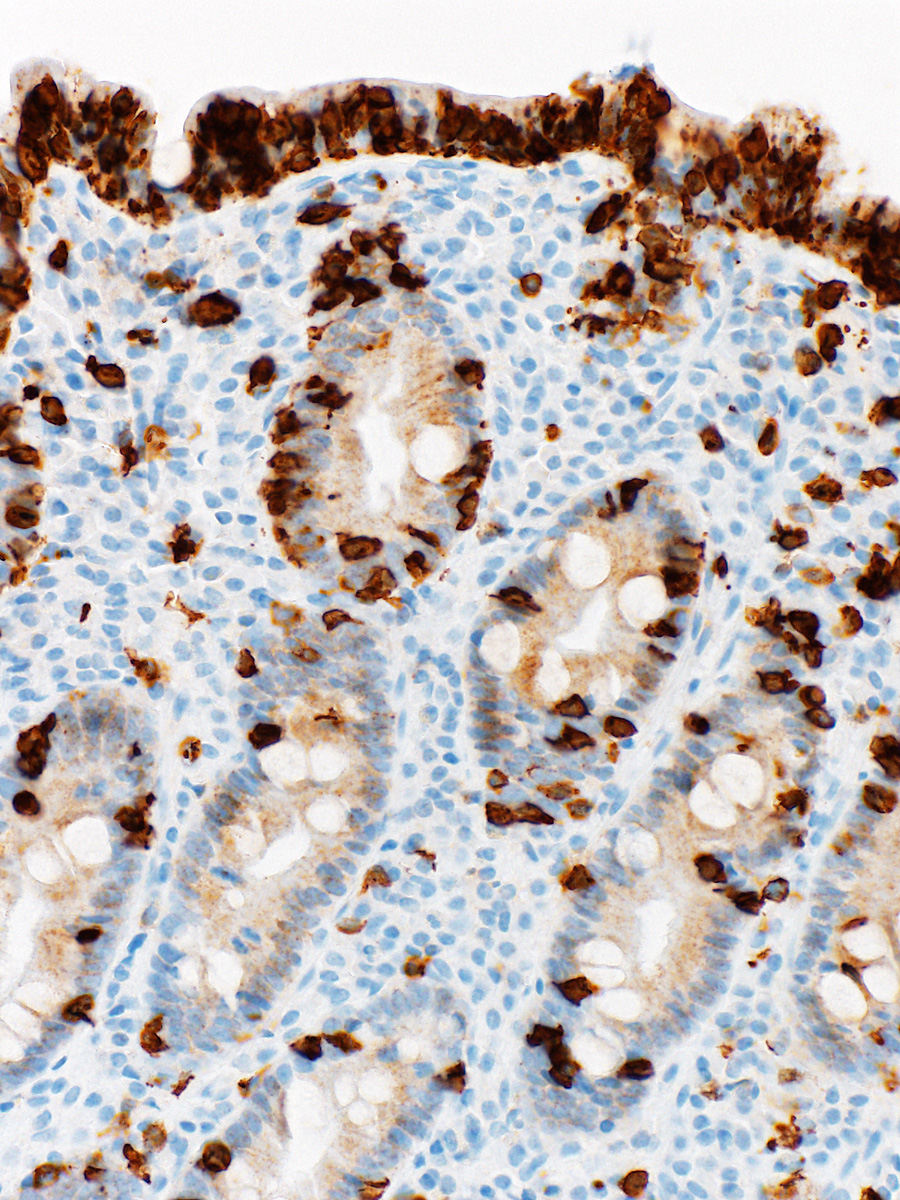

PathoPic – image database / PathoPic ID 11214 - Refraktäre Sprue Typ I Marsh-Oberhuber Klassifikation IIIc
de
Diagnose
Refraktäre Sprue Typ I Marsh-Oberhuber Klassifikation IIIc
Diagnose Gruppe
Systemerkrankung/Immunpathologie
Topographie
Duodenum
Topographie Gruppe
Darm, Anus
Beschreibung
Duodenalschleimhautbiopsie mit vollständiger Zottenatrophie (Marsh-Oberhuber Klassifikation IIIc mit flacher Schleimhaut) und deutlicher Kryptenhyperplasie. Intraepitheliale Lymphozytose. Die T-Lymphozyten exprimieren CD8.
Zusatzbefund
Intraepitheliale Lymphozytose (bis zu 80 Lymphozyten pro 100 Enterozyten). Die lymphozytäre Population besteht aus CD3 und CD8 positiven Lymphozyten.
Klinik
49 jähriger Patient mit therapierefraktärer Sprue unter glutenfreier Diät.
Kommentar
Die Diagnose einer refraktären Sprue basiert auf der Persistenz der Erkrankung trotz strikter Einhaltung einer glutenfreien Diät. Der Immunphänotyp der intraepithelialen Lymphozyten (CD3+/CD8+) ist beim Typ I der refraktären Sprue normal, die Lymphozyten sind polyklonal. Die refraktäre Sprue vom Typ I nimmt in den meisten Fällen einen benignen Verlauf. Obwohl selten, kann die refraktäre Sprue vom Typ I in eine refraktäre Sprue Typ II übergehen. Beim Typ II der refraktären Sprue sind die T-Lymphozyten klonal und können sich weiterentwickeln zu einem Enteropathie-assoziierten T-Zell Lymphom.
Bilder Typ
Histologie
Immunhistochemie
CD8
Vergrösserung
200
Alter
49
Geschlecht
männlich
Datum
Ersteintrag: 23.11.2012
Update: 04.06.2013